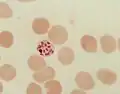
Reifer Schizont

Plasmodium falciparum
| Plasmodium falciparum | ||||||||||||
|---|---|---|---|---|---|---|---|---|---|---|---|---|

Verschiedene Formen von Plasmodium falciparum im gefärbten Blutausstrich | ||||||||||||
| Systematik | ||||||||||||
| ||||||||||||
| Wissenschaftlicher Name | ||||||||||||
| Plasmodium falciparum | ||||||||||||
| (Welch), 1897 |
Plasmodium falciparum ist eine Art eines einzelligen Parasiten aus der Gattung Plasmodium, die als Krankheitserreger der lebensgefährlichen Malaria tropica beim Menschen überragende Bedeutung hat. Die Weltgesundheitsorganisation schätzt, dass 2006 rund 247 Millionen Malariafälle zu annähernd 881.000 Todesfällen führten, die weitaus meisten davon durch Plasmodium falciparum.[1] Andere Autoren kommen für 2002 auf 515 Millionen Malariafälle pro Jahr durch Plasmodium falciparum.[2]
Plasmodium falciparum unterscheidet sich in vielen Merkmalen von anderen Malariaerregern und wird deshalb zusammen mit einem Schimpansen infizierenden Parasiten in eine eigene Untergattung Laverania eingeordnet. Der Mensch ist der einzige natürliche Wirt. Plasmodium falciparum wird von weiblichen Stechmücken der Gattung Anopheles übertragen, in denen auch eine geschlechtliche Vermehrung erfolgt. Der Parasit ist heute vorwiegend in tropischen Ländern verbreitet, die weitaus meisten Fälle von Malaria tropica gibt es in Afrika südlich der Sahara.
Plasmodium falciparum hat einen komplexen Lebenszyklus, bei dem nach der Infektion eines Menschen auf eine erste Vermehrung in der Leber eine starke Vermehrung im Blut folgt. Durch einige Besonderheiten der Vermehrung im Blut, wie die oft hohe Zahl an Parasiten, das Anhaften von infizierten Blutzellen an Wände der Blutgefäße und die Rosettenbildung infizierter Zellen mit anderen Blutzellen, ist der Krankheitserreger besonders gefährlich. Plasmodium falciparum hat besondere molekulare Mechanismen entwickelt, die gleichzeitig dazu dienen, der Wirkung des Immunsystems des Menschen zu entgehen.
Entdeckung und Beschreibung
Geschichte

Plasmodium falciparum wurde erstmals 1880 von Alphonse Laveran im Blutausstrich eines in Algerien an Malaria erkrankten Soldaten identifiziert. Der von Laveran im nicht fixierten mikroskopischen Präparat beobachtete Prozess der Exflagellation, bei dem aus einem Mikrogametozyten, einer Geschlechtsform des Parasiten, in kurzer Zeit mehrere bewegliche männliche Gameten entstehen, war der Beleg dafür, dass die im Blut beobachteten Partikel keine Artefakte, sondern Lebensformen eines einzelligen Blutparasiten waren.
Laveran ging von nur einer Art des Malariaerregers beim Menschen aus, die er Oscillaria malariae nannte. Andere Autoren vermuteten unterschiedliche Erreger für die verschiedenen Formen der Malaria. Ettore Marchiafava und Angelo Celli führten 1885 den Gattungsnamen Plasmodium für die Malariaerreger ein. Der Erreger der Malaria tropica wurde 1897 von William Henry Welch nach Sichtung der Literatur Haematozoon falciparum genannt. Das Epitheton falciparum leitet sich vom lateinischen Wort Falx für Sichel ab und bezieht sich auf die charakteristische sichelförmige Gestalt der Gametozyten. Zwischen 1885 und 1897 wurden noch eine Reihe von anderen Namen von verschiedenen Autoren vorgeschlagen; entgegen der Prioritätsregel setzte sich in der Literatur die Bezeichnung Plasmodium falciparum durch. 1915 schlug Ziemann den Namen Plasmodium perniciosum vor. 1954 wurde das Epitheton falciparum vom ICZN für gültig erklärt, und zwar sowohl in der üblichen Kombination Plasmodium falciparum als auch in der nicht gebräuchlichen Bezeichnung Laverania falciparum.
Morphologie
Wie alle Plasmodien kommt P. falciparum in verschiedenen Entwicklungsstadien vor, von denen die Blutformen die bekanntesten und für die Diagnostik wichtigsten sind. Die aus den Mücken stammenden Sporozoiten sind sichelförmig und üblicherweise 10,5 bis 12 Mikrometer lang. Leberschizonten, die erste Entwicklungsform im Menschen, sind erst rund bis oval, in späten Stadien haben sie oft eine unregelmäßige, gelappte Form und erreichen eine Größe von bis zu 60 Mikrometern. Sie enthalten zehntausende von Merozoiten, welche jeweils einen Durchmesser von zirka 0,7 Mikrometer haben.
Bei der Vermehrung im Blut in Erythrozyten ist eine hohe Parasitämie ebenso typisch für diesen Erreger wie die häufige Abwesenheit später Entwicklungsformen im peripheren Blut; im Blutausstrich werden normalerweise fast nur Ringformen und nach längerer Krankheit auch reife Gametozyten beobachtet. Im Verlauf der Entwicklung in den Erythrozyten werden zuerst ringförmige Trophozoiten gebildet, die kleiner sind als bei anderen Malariaerregern des Menschen. Eine Infektion einer Blutzelle durch mehrere Merozoiten ist häufig. Erythrozyten mit älteren, größeren Ringformen zeigen nach Färbung oft eine typische Maurersche Fleckung. Im weiteren Verlauf der Entwicklung werden die Parasiten größer und kompakter, ohne amöboide Formen zu bilden, wie dies bei manchen anderen Malariaerregern der Fall ist. Im gefärbten Blutausstrich ist das Zytoplasma in diesem Stadium tiefblau gefärbt, Malariapigment ist erstmals in diesem Stadium erkennbar.
Spätere Entwicklungsformen werden meist nur in geringer Zahl im Blutausstrich beobachtet. Durch Mehrfachteilung wird aus dem Trophozoiten ein Schizont, der sich vergrößert und den größten Teil des Erythrozyten ausfüllt. Reife Blutschizonten enthalten 8 bis 20, typischerweise 16 Merozoiten. Die manchmal genannte Zahl von bis zu 32 Merozoiten liegt vermutlich an einer Mehrfachinfektion mit zwei Schizonten in einem Erythrozyten. Beim sonst morphologisch von P. falciparum kaum unterscheidbaren P. reichenowi beschränkt sich die Zahl der Merozoiten auf 10 bis 12.
Auch unreife Gametozyten werden relativ selten im peripheren Blut beobachtet. Charakteristisch für die Art ist die sichelförmige Gestalt der reifen Gametozyten, eine Eigenschaft, die bei Säugetiere infizierenden Plasmodien nur in der Untergattung Laverania beobachtet wurde. Die Makrogametozyten sind relativ schlank, das Zytoplasma ist nach Färbung deutlich blau, der Zellkern kompakt. Die Mikrogametozyten dagegen sind von der Form her plumper, das Zytoplasma ist nach Färbung hellblau, der Zellkern größer und weniger kompakt.
Als Apicomplexa verfügen Plasmodien über ein spezielles Organell, den Apicoplast. Dieser Plastid, der vermutlich durch Endosymbiose von Rotalgen entstanden ist,[3][4] hat seine Fähigkeit zur Photosynthese verloren, ist aber im Stadium der Gametozytogenese (der asexuellen Entwicklungsstadien in den Erythrozyten und in der Leber) lebensnotwendig für Plasmodien.[5] Daher stellt der Apicoplast ein attraktives Ziel für Anti-Malaria-Medikamente dar.[6][7]
- Entwicklungsformen im gefärbten Blutausstrich
-
 Junger Trophozoit (Siegelringstadium). Balken 10 Mikrometer
Junger Trophozoit (Siegelringstadium). Balken 10 Mikrometer -
Reifer Schizont
Reifer Schizont -
 Aufplatzender Schizont
Aufplatzender Schizont -
 Gametozyt
Gametozyt
Systematik

Der ursprüngliche Wirt von P. falciparum ist der Westliche Gorilla (Gorilla gorilla). Nach einer 2010 veröffentlichten Studie ist der Erreger ein einziges Mal von einem Gorilla auf einen Menschen übertragen worden.[8] 2019 wurde der Übergang auf den Menschen als Folge eines Gentransfers von Plasmodium adleri auf Plasmodium falciparum vor rund 50.000 Jahren beschrieben.[9]
Im Unterschied zu den anderen Malariaerregern des Menschen wird P. falciparum nicht in die Untergattung Plasmodium, sondern in eine eigene Untergattung Laverania eingeordnet. Zu den Laverania gehören insgesamt sechs verschiedene Plasmodium-Arten, die den Gemeinen Schimpansen (Pan troglodytes) und den Westlichen Gorilla, nicht jedoch den Östlichen Gorilla (Gorilla beringei) und den Bonobo (Pan paniscus) infizieren. Das morphologisch fast identische P. reichenowi, ein Schimpansen-Parasit, stand lange im Verdacht der Ursprung von P. falciparum zu sein.[8]
Obwohl zwischen verschiedenen Isolaten von P. falciparum oft morphologische, immunologische und genetische Unterschiede feststellbar sind, hat sich keine taxonomische Differenzierung der Art beispielsweise in Unterarten durchsetzen können, da die verschiedenen Merkmale nicht konstant und verschieden genug sind, um eine entsprechende Abgrenzung zu rechtfertigen. Bei populationsgenetischen Untersuchungen wurden in Teilen des Genoms und im Mitochondriengenom von P. falciparum erstaunlich wenige Polymorphismen gefunden. Die derzeit plausibelste Erklärung dafür ist eine mögliche schnelle Expansion einer kleinen Parasitenpopulation in Afrika vor zirka 10.000 Jahren.[10] Diese Expansion nach einem genetischen Flaschenhals könnte zeitgleich mit Änderungen der Ökologie des Menschen, dem einzigen Säugetierwirt des Parasiten, in der neolithischen Revolution verlaufen sein.
Verbreitung und Wirte
Verbreitung

Plasmodium falciparum kann in tropischen und subtropischen Gegenden vorkommen. Heute ist P. falciparum vorwiegend in den Tropen, insbesondere in Afrika südlich der Sahara, verbreitet. Weitere Schwerpunkte liegen in Teilen Süd- und Südostasiens und auf Papua-Neuguinea sowie im Amazonasbecken. Insgesamt lebt mehr als 40 % der Weltbevölkerung in Regionen mit Infektionsrisiko durch P. falciparum.[11] Als generelle Regel wird oft angegeben, die Parasiten würden in den Tropen bis zu einer Meereshöhe von 1.500 Metern übertragen, es gibt aber auch nachgewiesene Fälle von Übertragungen aus 2.600 bis 2.800 Metern Höhe.
Bis zur Mitte des 20. Jahrhunderts kam der Parasit auch im Mittelmeerraum, in Europa beispielsweise in Spanien, Italien und auf dem Balkan, sowie im Südosten der USA vor. In Mitteleuropa war P. falciparum im Gegensatz zu anderen Malariaerregern nie heimisch. Ein natürlicher Verbreitungszyklus von Mensch zu Mensch durch Mücken beschränkt sich hier auf extrem seltene Einzelfälle, für die ein nicht erkannter Parasitenträger, eine geeignete Anopheles-Population und eine die Vermehrung des Parasiten in der Mücke begünstigende längere Hitzeperiode zusammenkommen müssen.[12]
Durch Genanalyse wurde festgestellt, dass die Erreger in Südamerika aus Afrika südlich der Sahara stammen, also mit dem atlantischen Sklavenhandel eingeschleppt wurden. Die Autoren vermuten, dass die zwei genetischen Hauptstränge in Südamerika (ein nördlicher und ein südlicher) unabhängig voneinander eingeschleppt wurden.[13]
Säugetierwirte
Unter natürlichen Bedingungen wird nur der Mensch mit P. falciparum infiziert, andere relevante Reservoirwirte sind nicht bekannt. Experimentell können Schimpansen durch Mücken mit P. falciparum infiziert werden; die Entwicklung beschränkt sich aber auf die Vermehrungsphase in der Leber. Wird Schimpansen die Milz entfernt, können sich die Parasiten auch im Blut vermehren, es werden aber keine reifen Gametozyten beobachtet. Auch Gibbons können infiziert werden, produzieren aber ebenfalls keine reifen Gametozyten.
Große Bedeutung für die Malariaforschung haben Nachtaffen aus Südamerika, die experimentell mit P. falciparum infiziert werden können. Beim Grauhand-Nachtaffen gelingt sogar reproduzierbar ein vollständiger Entwicklungszyklus mit der Übertragung des Parasiten von Affe zu Affe durch Stechmücken.[14] Dieses Tiermodell wurde seit 1976 durch die wichtige Möglichkeit ergänzt, P. falciparum in kontinuierlicher Zellkultur in menschlichen Erythrozyten zu erforschen.[15]
Insektenwirte

Eine große Zahl an Stechmückenarten ist in der Lage, P. falciparum zu übertragen. Bei Garnham (1966) werden 66 Arten aus der Gattung Anopheles als geeignete Vektoren genannt. Große epidemiologische Bedeutung hat Anopheles gambiae sensu stricto im tropischen Afrika, da diese Mücke bevorzugt Menschen sticht und damit die Verbreitung des Parasiten begünstigt. Zu den geeigneten Vektoren zählen mit Anopheles atroparvus, Anopheles messeae und möglicherweise Anopheles plumbeus auch in Europa vorkommende Arten. Nicht alle Mückenarten sollen für alle P. falciparum-Parasiten geeignet sein; so sollen sich afrikanische Parasiten nicht in europäischen Mücken der Art Ano. atroparvus vermehren.
Lebenszyklus
Der Lebenszyklus von P. falciparum gleicht mit seinem obligaten Wirtswechsel zwischen Anopheles-Mücken und dem Menschen dem Zyklus anderer Plasmodien, weist aber im Vergleich mit den anderen Malariaerregern des Menschen eine Reihe von Besonderheiten auf, die teilweise wichtige Konsequenzen für den Krankheitsverlauf haben.
Infektion und Vermehrung in der Leber
Die Sporozoiten gelangen durch infizierte Stechmücken in die Blutbahn des Menschen, wandern von dort in die Leber und dringen in Hepatozyten ein, in denen sie sich ungeschlechtlich durch Schizogonie vermehren. Die Inkubationszeit dieser Leberphase beträgt mindestens fünfeinhalb Tage. Die Leberschizonten produzieren jeweils bis zu 40.000 Merozoiten, die in die Blutbahn freigesetzt werden und Erythrozyten aller Reifestadien befallen. Im Gegensatz zu manchen anderen Malariaerregern gibt es bei P. falciparum nur einen einzigen Vermehrungszyklus im Gewebe, Dauerformen des Parasiten in der Leber wurden nicht beobachtet.
Vermehrung im Blut
Mikroskopisch sind Parasiten im Blut frühestens sieben Tage nach der Infektion nachweisbar, typischerweise beträgt die Präpatenz ungefähr elf Tage. In den Erythrozyten findet eine weitere ungeschlechtliche Vermehrung statt (hier spielt das Transportprotein Anionen-Austauscher 1 die Rolle der Eintrittspforte). Die Generationszeit bei der Vermehrung in den Erythrozyten beträgt im Mittel 48 Stunden, eine Synchronisierung der Vermehrung mit einem ausgeprägten Fieberzyklus ist im Gegensatz zu den anderen Malariaerregern des Menschen aber selten. Im Erythrozytenzyklus von P. falciparum im peripheren Blut werden jeweils nur in den ersten 24 Stunden befallene Zellen in großer Zahl nachgewiesen, Schizonten werden dort nur relativ selten beobachtet. Dies liegt daran, dass die infizierten Erythrozyten mit reifenden Schizonten in postkapillaren Venolen in verschiedenen Organen verbleiben, wo sie an das Endothel der Blutgefäße anhaften, um so einer Eliminierung in der Milz zu entgehen. Ein ähnliches Verhalten zeigen viele Tiere infizierende Plasmodium-Arten, besonders ausgeprägt ist es bei manchen Erregern der Affenmalaria wie P. coatneyi und dem nah mit P. falciparum verwandten P. reichenowi. Eine weitere Eigenschaft von P. falciparum ist eine Rosettenbildung infizierter Erythrozyten mit nicht infizierten Erythrozyten. Durch die Kombination von an Kapillarwänden haftenden infizierten Erythrozyten und Rosettenbildung können feine Kapillaren in lebenswichtigen Organen wie dem Gehirn blockiert und so die Sauerstoffversorgung beeinträchtigt werden. Dies kann zum oft tödlichen Krankheitsverlauf der schweren Malaria tropica beitragen.
Geschlechtliche Vermehrung
Einige wenige Plasmodien entwickeln sich in den Erythrozyten zu Geschlechtsformen, den Gametozyten. Diese werden typischerweise acht bis elf Tage nach dem ersten Auftreten der ungeschlechtlichen Formen im Blut beobachtet, im Vergleich zu anderen Plasmodien-Arten verläuft die Entwicklung der Gametozyten sehr langsam. Ungewöhnlich ist auch, dass im peripheren Blut nur reife Gametozyten beobachtet werden. Die Reifung der Gametozyten erfolgt im Knochenmark, wo mit sich entwickelnden Gametozyten infizierte Erythrozyten durch Zelladhäsionsmoleküle gebunden werden.[16] Die reifen Mikrogametozyten und Makrogametozyten können von Stechmücken bei einer Blutmahlzeit aufgenommen werden und im Darm des Insekts einen neuen Entwicklungszyklus in Gang setzen. Nach einer Verschmelzung der Gameten werden im Darm neue Sporozoiten gebildet, die in die Speicheldrüse der Mücke wandern, von wo sie auf einen neuen Wirt übertragen werden können. Die Entwicklungszeit von P. falciparum in der Mücke beträgt bei 20 °C zirka 23 Tage, bei 25 °C zirka zehn Tage und bei 30 °C zirka neun Tage. In der Speicheldrüse der Mücke behalten die Sporozoiten ihre Infektiosität für 40 bis 55 Tage.
Molekulare Eigenschaften
Aufgrund der überragenden medizinischen Bedeutung als Krankheitserreger wurde P. falciparum umfassend untersucht, um neue Ansätze zur Prophylaxe und zur Therapie zu identifizieren. Dabei lagen Schwerpunkte auf den Mechanismen der besonderen Pathophysiologie der Malaria tropica, aber auch auf den Mechanismen, mit denen P. falciparum die Aktivität des Immunsystems der Patienten unterläuft.
Parasiten-Wirt-Interaktionen
Im Inneren von Wirtszellen lebende Parasiten wie die Plasmodien benötigen in der Regel Wirtsfaktoren, um geeignete Zellen zu erkennen und in diese einzudringen. P. falciparum nutzt in verschiedenen Stadien eine ganze Reihe von Proteinen, um mit menschlichen Zellen zu interagieren.
Um in Erythrozyten einzudringen, benötigen die Merozoiten der Plasmodien bestimmte Rezeptoren auf der Zelloberfläche der Wirtszellen. P. falciparum kann hierfür mehrere Wege nutzen und bei Bedarf zwischen diesen wechseln. Wichtige Rezeptoren hierbei sind die Glykophorine auf den Erythrozyten und der Anionen-Austauscher 1. Diese Glykoproteine müssen ein bestimmtes Glykosylierungsmuster aufweisen, um eine Bindung des Parasitenproteins EBA175 und eine erfolgreiche Infektion zu ermöglichen. In der Abhängigkeit von diesem Glykosylierungsmuster liegt auch eine Ursache für die hohe Wirtsspezifität des Parasiten.[17]
Bei der für P. falciparum typischen Sequestrierung der infizierten Erythrozyten in den Blutgefäßen der Organe spielt das sogenannte PfEMP1 (P. falciparum erythrocyte membrane protein 1) eine zentrale Rolle.[18] Das Protein wird vom Parasiten produziert und auf der Oberfläche des infizierten Erythrozyten präsentiert. Dort kann PfEMP1 auf Endothelzellen in der Blutkapillare an verschiedene Rezeptoren wie beispielsweise CD36 binden und über diese Bindung den infizierten Erythrozyten an die Blutgefäßwand anheften. Eine bestimmte Form von PfEMP1 kann an Chondroitinsulfat in der Plazenta binden und damit zu einem problematischen Krankheitsverlauf während einer Schwangerschaft beitragen. Schließlich kann PfEMP1 an den Komplementrezeptor 1 auf Erythrozyten binden und über diesen eine Rosettenbildung von infizierten und nicht infizierten Erythrozyten initiieren. All diese von PfEMP1 ausgehenden Interaktionen mit Wirtsrezeptoren spielen vermutlich beim Krankheitsverlauf eine Rolle.
Antigenvariabilität
P. falciparum nutzt wie alle Plasmodien eine ganze Reihe von Mechanismen, um der Immunabwehr des Wirtes zu entgehen. Auch hier spielt das PfEMP1 eine zentrale Rolle.[18] Da PfEMP1 auf der Zelloberfläche der Erythrozyten präsent ist, werden vom Patienten Antikörper gegen das Parasitenprotein gebildet. Um diese Immunreaktion zu unterlaufen, kann P. falciparum das PfEMP1 austauschen. PfEMP1 wird von einer Multigenfamilie mit zirka 60 var-Genen kodiert, von denen zu jedem Zeitpunkt immer nur eines aktiv ist. Wird das aktive var-Gen gewechselt und ein anderes PfEMP1 produziert, so läuft die erworbene Immunität des Patienten oft ins Leere. In Malaria-Endemiegebieten dauert es viele Jahre, bis die Menschen gegen die verschiedenen Parasitenantigene zumindest eine teilweise Immunität erworben haben. Verschiedene PfEMP1-Proteine von verschiedenen var-Genen können ein unterschiedliches Spektrum an Endothel-Rezeptoren binden. Ob bestimmte PfEMP1-Proteine und ihre Bindung an organspezifische Rezeptoren für besonders schwere Krankheitsverläufe wie die zerebrale Malaria verantwortlich sind, ist nicht gesichert. Derzeit ist die Rolle der an die Plazenta bindenden PfEMP1-Form im Zusammenhang mit dem Verlauf der Malaria während einer Schwangerschaft am besten verstanden. Außer bei P. falciparum wurde die var-Genfamilie nur noch beim nah verwandten P. reichenowi gefunden.
Genom
Zum besseren Verständnis der Biologie des Parasiten wurde das Genom im Jahre 2002 vollständig sequenziert.[19] Es umfasst zirka 23,3 Megabasenpaare auf 14 Chromosomen, die zirka 5.400 Gene enthalten, deren Funktion allerdings oft unbekannt ist.[20] Ungewöhnlich im Vergleich zu anderen Plasmodien ist ein sehr niedriger GC-Gehalt von weniger als 20 %, ein Extremwert innerhalb der Eukaryoten. Wie bei allen Plasmodien ist das Genom reich an repetitiven Sequenzen. Viele für die Antigenvariabilität bei P. falciparum verantwortliche Genfamilien sind an den Telomeren der Chromosomen lokalisiert und spezifisch für die Untergattung Laverania.
Einzelnachweise
- ↑ WHO: World Malaria Report 2008 (PDF)
- ↑ R. W. Snow, C. A. Guerra, A. M. Noor, H. Y. Myint, S. I. Hay: The global distribution of clinical episodes of Plasmodium falciparum malaria. In: Nature. 434(7030), 10. Mar 2005, S. 214–217. PMID 15759000
- ↑ B. Striepen: The apicoplast: a red alga in human parasites. In: Essays Biochem. 51, 2011, S. 111–125. PMID 22023445
- ↑ M. Kalanon, G. I. McFadden: Malaria, Plasmodium falciparum and its apicoplast. In: Biochem Soc Trans. Band 38, Nr. 3, Juni 2010, S. 775–782. PMID 20491664
- ↑ J. D. Wiley u. a.: Isoprenoid precursor biosynthesis is the essential metabolic role of the apicoplast during gametocytogenesis in Plasmodium falciparum. In: Eukaryot. Cell. Band 14, Nr. 2, Februar 2015, S. 128–139. PMID 25446055
- ↑ J. Wiesner, H. Jomaa: Isoprenoid biosynthesis of the apicoplast as drug target. In: Curr Drug Targets. Band 8, Nr. 1, Januar 2007, S. 3–13. PMID 17266527
- ↑ A. Mukherjee, G. C. Sadhukhan: Anti-malarial Drug Design by Targeting Apicoplasts: New Perspectives. In: J Pharmacopuncture. Band 19, Nr. 1, März 2016, S. 7–15. PMID 27280044
- ↑ a b Liu Weimin u. a.: Origin of the human malaria parasite Plasmodium falciparum in gorillas. In: Nature. Band 467, Nr. 7314, 2010, S. 420–425.
- ↑ Francis Galaway et al.: Resurrection of the ancestral RH5 invasion ligand provides a molecular explanation for the origin of P. falciparum malaria in humans. In: PLoS Biology. Band 17, Nr. 10, e3000490, doi:10.1371/journal.pbio.3000490.
Resurrection of 50,000-year-old gene reveals how malaria jumped from gorillas to humans. Auf: eurekalert.org vom 15. Oktober 2019. - ↑ D. L. Hartl: The origin of malaria: mixed messages from genetic diversity. In: Nat Rev Microbiol. Band 2, Nr. 1, 2004, S. 15–22. PMID 15035005
- ↑ S. I. Hay, C. A. Guerra, P. W. Gething, A. P. Patil, A. J. Tatem, A. M. Noor, C. W. Kabaria, B. H. Manh, I. R. Elyazar, S. Brooker, D. L. Smith, R. A. Moyeed, R. W. Snow: A World Malaria Map: Plasmodium falciparum Endemicity in 2007. In: PLoS Med. Band 6, Nr. 3, 24. Mar 2009, S. e48. PMID 19323591
- ↑ A. Krüger, A. Rech, X. Z. Su, E. Tannich: Two cases of autochthonous Plasmodium falciparum malaria in Germany with evidence for local transmission by indigenous Anopheles plumbeus. In: Trop Med Int Health. Band 6, Nr. 12, 2001, S. 983–985. PMID 11737834
- ↑ Malaria: Ausbreitung durch Sklavenhandel. science.orf.at, 27. Dezember 2011.
- ↑ S. Herrera, B. L. Perlaza, A. Bonelo, M. Arévalo-Herrera: Aotus monkeys: their great value for anti-malaria vaccines and drug testing. In: Int J Parasitol. Band 32, Nr. 13, 4. Dez 2002, S. 1625–1635. PMID 12435447
- ↑ W. Trager, J. B. Jensen: Human malaria parasites in continuous culture. In: Science. Band 193, 1976, S. 673–675. PMID 781840.
- ↑ P. Alano: Plasmodium falciparum gametocytes: still many secrets of a hidden life. In: Mol Microbiol. Band 66, Nr. 2, 2007, S. 291–302. PMID 17784927
- ↑ D. Chattopadhyay, J. Rayner, A. M. McHenry, J. H Adams: The structure of the Plasmodium falciparum EBA175 ligand domain and the molecular basis of host specificity. In: Trends Parasitol. Band 22, Nr. 4, 2006, S. 143–145. PMID 16497558
- ↑ a b S. A. Kyes, S. M. Kraemer, J. D. Smith: Antigenic variation in Plasmodium falciparum: gene organization and regulation of the var multigene family. In: Eukaryot Cell. Band 6, Nr. 9, Sep 2007, S. 1511–1520. PMID 17644655
- ↑ M. J. Gardner u. a.: Genome sequence of the human malaria parasite Plasmodium falciparum. In: Nature. Band 419, 3. Oktober 2002, S. 498–511.
- ↑ T. W. Kooij, C. J. Janse, A. P. Waters: Plasmodium post-genomics: better the bug you know? In: Nat Rev Microbiol. Band 4, Nr. 5, 2006, S. 344–357. PMID 16582929
Literatur
- G. Robert Coatney, William E. Collins, McWilson Warren, Peter G. Contacos: The primate malarias. U.S. National Institute of Allergy and Infectious Diseases, Bethesda 1971, Kapitel 22, S. 263 ff.: Plasmodium falciparum (PDF)
- Percy Cyril Claude Garnham: Malaria Parasites and other Haemosporidia. Blackwell Scientific Publications, Oxford 1966, ISBN 0-632-01770-8, Kapitel XIV, S. 357 ff.: Plasmodium falciparum and Plasmodium reichenowi.